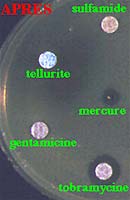

La résistance acquise des bactéries aux antibiotiques est devenue un réel problème de limitation des thérapeutiques actuelles et amène à sensibiliser le grand public à un usage beaucoup raisonné de ces médicaments.

Ce phénomène d'émergence de bactéries résistantes peu de temps après la commercialisation d'un antibiotique a "traumatisé" le monde scientifique dans les années 50-55 et a même conduit les scientifiques a pensé que les antibiotiques allaient être obsolètes à cause d'une extraordinaire aptitude génétique des bactéries à échanger du matériel génétique (R facteurs).
| Objectifs d'aujourd'hui : Pouvez-vous définir un plasmide ? Pouvez-vous préciser les propriétés biologiques codées par les plasmides ? Quelles ont été les conséquences médicales de ce type de transfert ? Etes-vous capable de définir brièvement la transposition et le transposon ? |
A - PLASMIDE: HISTORIQUE
|
* Au Japon dans les années 55-60, isolement d'entérobactéries multirésistantes (Shigella ) responsables de diarrhées.
* Par ailleurs, il y avait existence simultanée dans les selles de malades de souches d'Escherichia coli et de Shigella multirésistantes. * Selon le principe de la spécificité, la probabilité d'obtenir un mutant eut été de l'ordre de 10- 24. Or dans une selle, la population d'entérobactéries n'excéde pas 10 10. |
 |
Un nouveau chapitre de la génétique bactérienne était ouvert avec la découverte de ces ADN cytoplasmiques, dénommés, par la suite, plasmides.
B - DEFINITION
ADN à double brin, circulaire, cytoplasmique douées de réplication autonome et de taille variable. Ils sont médiateurs de nombreuses propriétés permettant une meilleure adaptation des bactéries, bien que non indispensables au métabolisme normal de la cellule-hôte (endosymbiotes). Leur transmission naturelle d'une cellule à l'autre s'effectue habituellement par conjugaison, quoique les autres modes de transfert soient possibles.
C - PRINCIPALES CARACTÉRISTIQUES

On notera l'addition de ces propriétés par une même souche :
 |
|
 |
|
 |
|
|
L'acquisition d'un ou plusieurs caractères métaboliques dont la production de SH2 (E. coli), de lysine décarboxylase (Proteus) ou encore l'utilisation de plusieurs hydrocarbures (camphre, toluène, xylène.....) peut amener à des erreurs de diagnostic au laboratoire ou à contruire certains "bugs" utiles pour dépolluer.
Les plasmides sans fonction connue sont dits cryptiques. |
 |
Autres propriétés :
Ils sont doués de réplication autonome, assurant sa survie ou son existence. Leur transmission d'une cellule à l'autre s'effectue habituellement par conjugaison (codent pour des pilis sexuels), ou encore transduction ou transformation, mais souvent sans spécificité d'hôte, d'où une diffusion entre espèces bactériennes différentes.
Voulez-vous voir une animation: http://www.fda.gov/cvm/antiresistvideo.htm
 |
 |
|
Nature - Structure :
ADN à double brin, circulaire, cytoplasmique de taille variable (0,5 kb à 500 kb). Peuvent être visualisés par microscopie électronique ou plus simplement par électrophorèse en gel d'agarose et révêlation au bromydrate d'éthidium (substance flurorescente). |
 |
| Voici le contenu plasmidique de plusieurs souches d'une entérobactérie dénommée Klebsiella pneumoniae |
Peuvent être coupés par diverses endonucléases, d'où une caractérisation possible par leur profil de restriction. |
 |
 |
Nomenclature :
p pour plasmide puis 2 ou 3 lettres selon les combinaisons et un chiffre : pIP15 pour Institut Pasteur, pSC102 pour Stanley Cohen, pUD12 pour Université Descartes..............
Classification :
A cause du grand nombre de combinaisons de caractères et du risque d' "épidémie planétaire", un classement a été proposé dans les années 70 en groupes ou classe d'incompatibilités (Inc).
Deux chefs dans le même bureau, que se passent-ils ? Il y a exclusion de l'un. Cette régle est applicable aux plasmides.
 |
 |
Ainsi ils appartiennent au même groupe s'il y a exclusion. Cette approche fastidieuse de classement au cours des années 70 a amené la découverte des gènes sauteurs ou mobiles.
D - CONCLUSION
Elèments de l'hérédité extrachromosomique, ils donnent aux nombreuses espèces qui les hébergent de nouveaux caractères. Il s'agit du principal processus d'évolution rapide des bactéries
TRANSPOSON
E - HISTORIQUE
Première évocation de gènes mobiles venue d'expériences de génétique chez le maïs. Lors de caractérisation de plasmide, il a été observé d'étranges recombinaisons de gènes de résistance aux antibiotiques tel le gène amp, s'accompagnant du même accroissement de taille du plasmide receveur. On avait la preuve directe d'une addition de matériel génétique (10 kb)(1974).
 |
 |
F - DEFINITION
transposons : séquences d'ADN capables de changer de localisation dans le génome sans jamais apparaitre à l'état libre. Ils ne peuvent se répliquer mais codent pour les déterminants de la transposition et ceux d'autres fonctions telle la résistance aux antibiotiques (cf propriétés biologiques des plasmides).
transposition : mécanisme d'évolution rapide consistant dans l'addition pure et simple de gènes (ADN) de taille définie au sein d'un génome (chromosome bactérien ou plasmide) et enl'absence d'homologie de séquence nucléotidique (recombinaison illégitime).
G - RÔLE - INTÉRÊT
Les transposons constituent un génome collectif ou un patrimoine génétique commun, dans lequel puissent les bactéries en fonction de leur nécessité d'adaptation ou de la pression de sélection. Ces élèments sont la preuve du "génie génétique in vivo". Il sont très utilisés en mutagénèse in vitro, ou encore par les bactéries elles-mêmes pour moduler l'expression d'un gène.
CONCLUSIONS
Il est assez curieux que le principal mécanisme d'apparition de nouvelles propriétès chez les bactéries soit en relation avec l'acquisition d'ADN soit de type plasmidique soit de type transposon. Cependant d'autres solutions génétiques ont été récemment découvertes avec la mise en évidence d'intégrons, par exemple. Cette extraordinaire aptitude du monde bactérien à s'adapter aux conditions environnantes montre leur supériorité et notre nécessaire adaptation telle l'usage de plus en plus ciblé des antibiotiques.
Ce cours a été préparé par le Professeur A. PHILIPPON (Faculté de Médecine COCHIN-PORT-ROYAL, Université PARIS V))(Octobre 2000)
Pour en savoir plus :

Validation de vos connaissances (QCM)
|
|
|
|
|